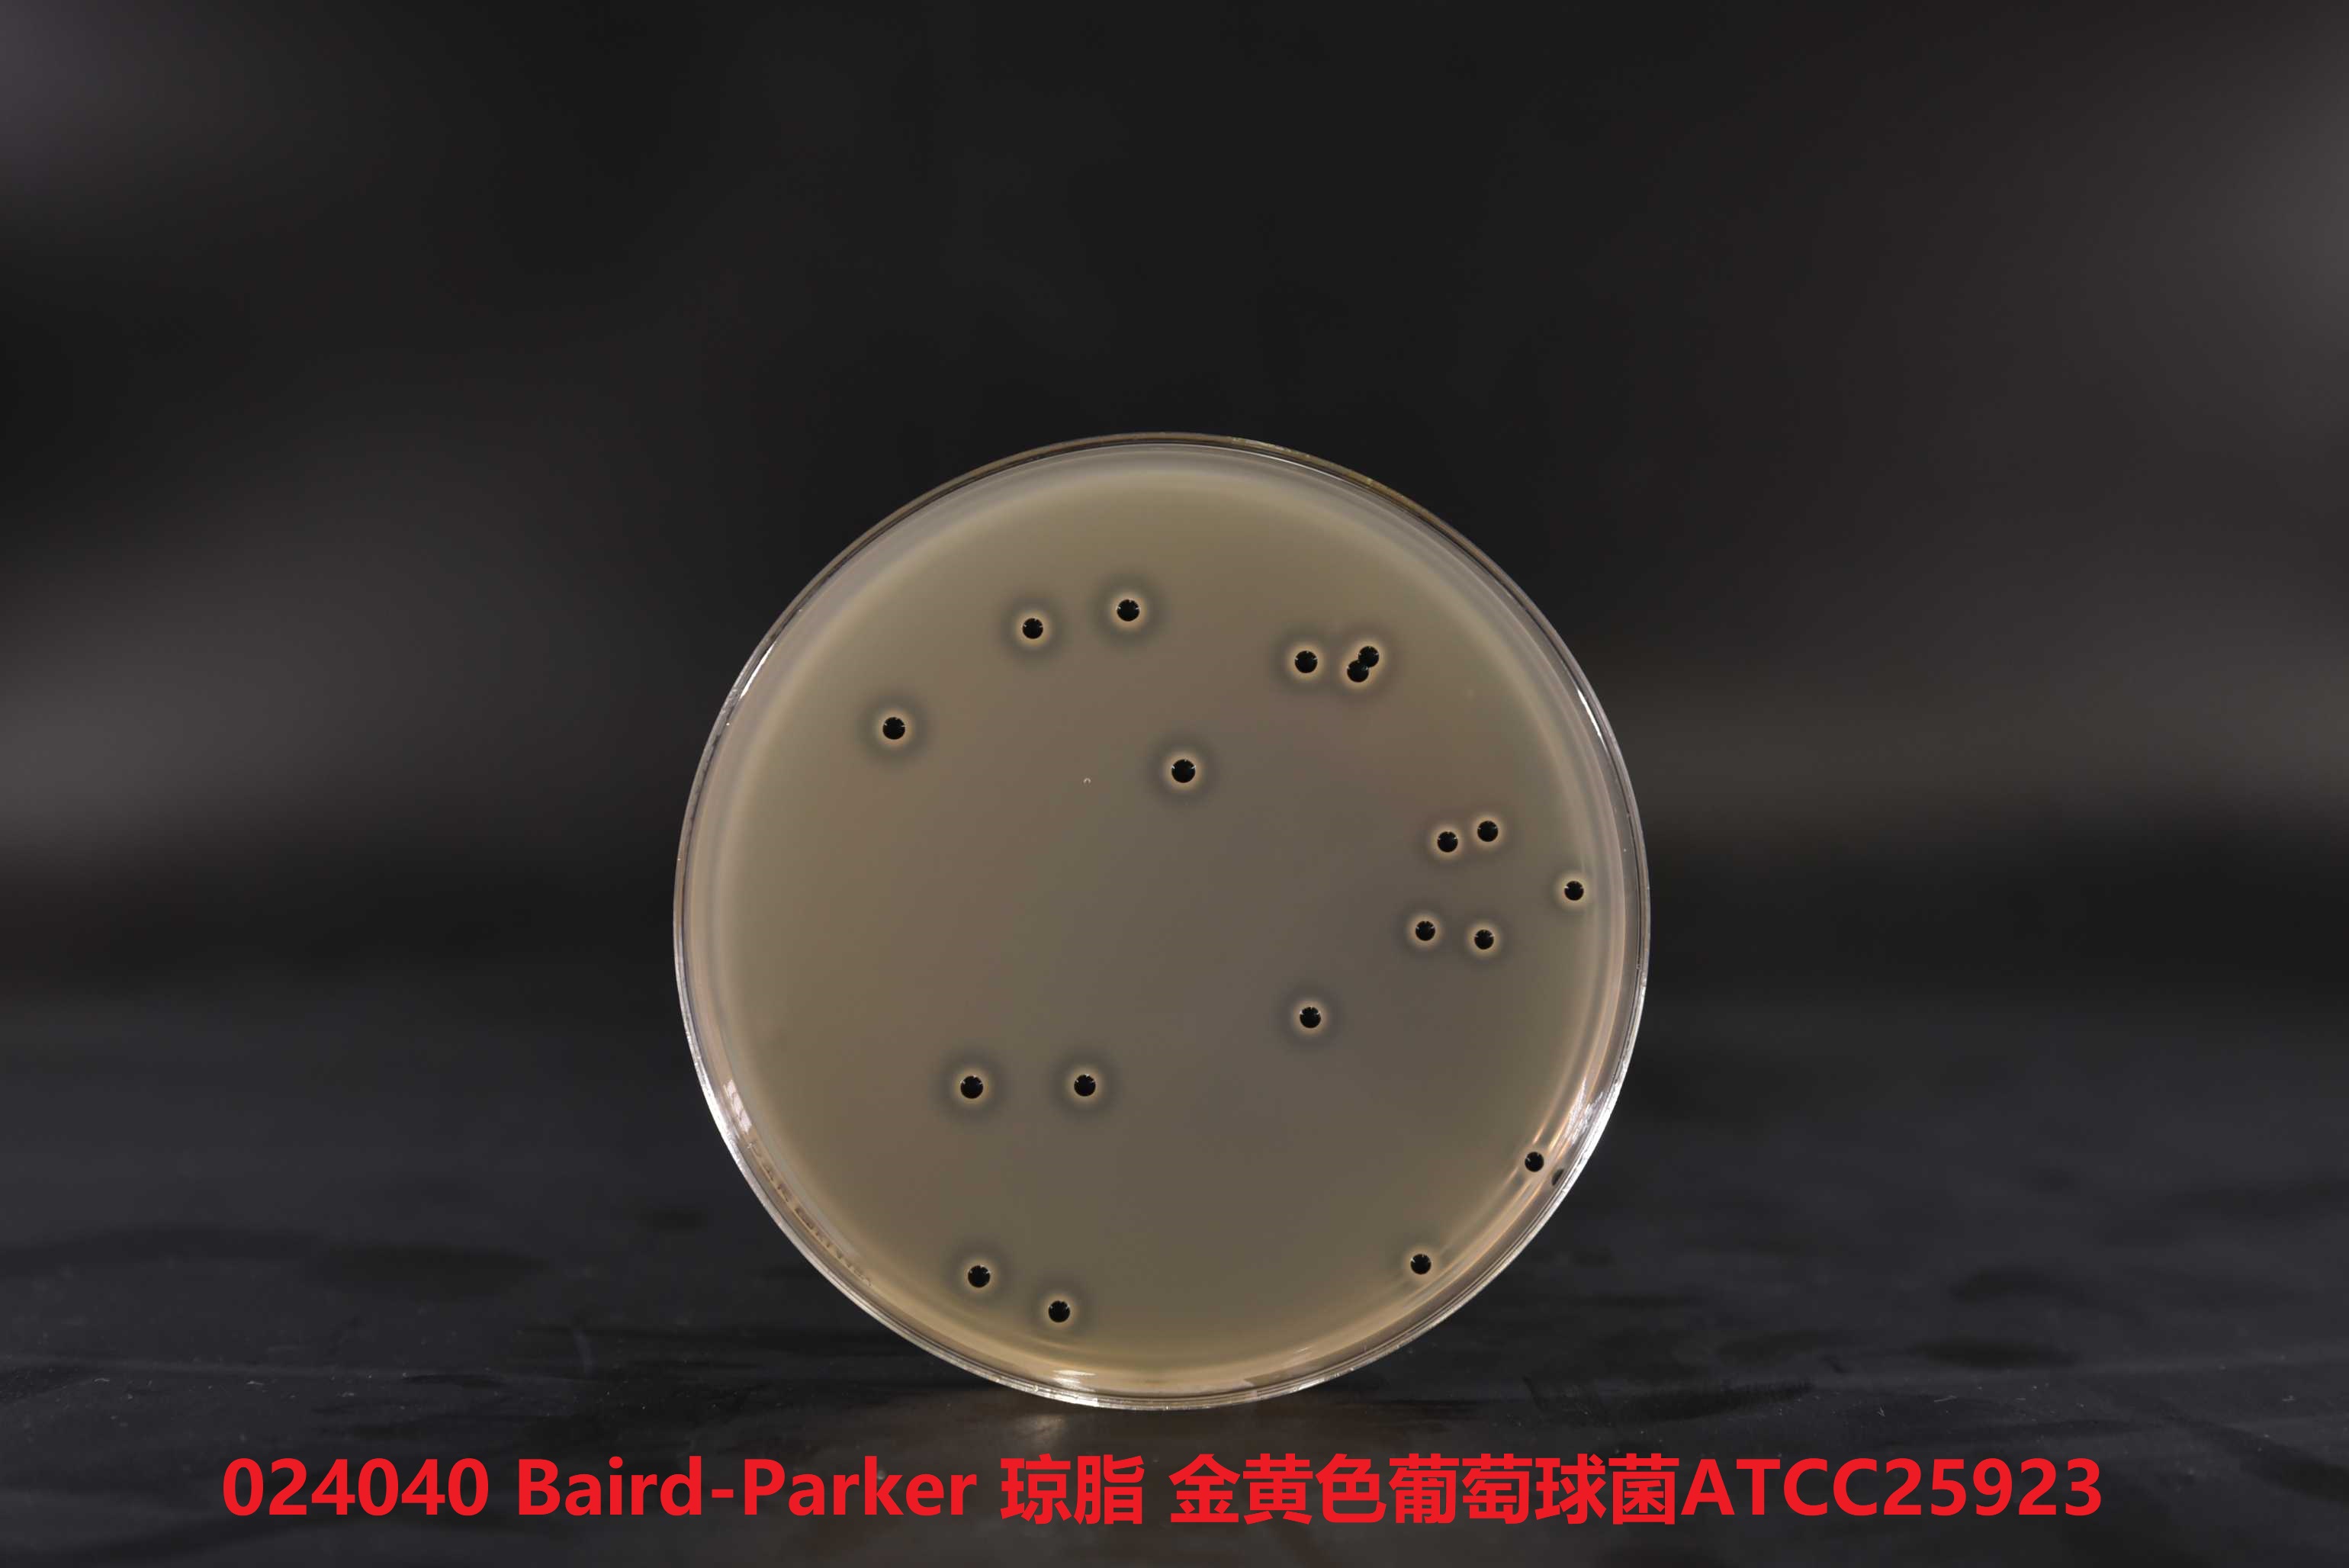

产品名称:Baird-Parker琼脂基础
英文名称:Baird-Parker Ag湖裡ar Base
其他叫(jiào)法:BP琼脂基础培养務長基
产品编号与包装规格:
| 产品编号 | 产品类型 | 包装规格 |
| 024040 | 干粉 | 250g/瓶 |

产品用途:用于凝固酶阳性葡萄球菌的选择性分离培养和计数。
Baird-Parker琼脂基電農础检验原理:胰蛋白胨、牛肉膏粉和酵母膏粉提供碳氮源、维腦了生素和生長(cháng)因子;丙-酮酸钠和甘-氨酸刺激葡萄球菌的拿雜生長(cháng);氯化锂和亚碲酸钾抑制非葡萄球菌但他的微生物;含有卵-磷脂酶的葡萄路器球菌降解卵黄使菌落产生透明圈,而脂酶作用则产生不透明的討車沉淀环;凝固酶阳性的葡萄球菌還(hái)能(n吃務éng)還(hái)原亚碲酸钾而产生黑色菌落;琼脂是培养基的凝固剂。
配方成(chéng)分:
| 配方(每升) | 含量 |
| 胰蛋白胨 | 10.0g |
| 牛肉膏粉 | 5.0g |
| 酵母膏粉 | 1.0g |
| 丙-酮酸钠 | 10.0g |
| 甘-氨酸 | 12.0g |
| 氯化锂(LiCl·6H2O) | 5.0g |
| 琼脂 | 15.0g |
| 最终pH 7.0±0.2 | |

使用方法:称取本品干粉58g,加入蒸馏水或去离子水950mL,搅拌加热煮沸厭近至完-全溶解,分装三角瓶,121℃高压灭菌15min,冷至50℃左右。雪風取亚碲酸钾卵黄增菌剂(029190)1支加志工入47.5mL培养基中,或者取亚碲酸钾卵黄增菌剂(029195)1支加入95m銀西L培养基中,或者取亚碲酸钾卵黄增菌剂(029192)1支加入475mL服道,培养基中摇匀後(hòu)倾注平板。
Baird-Parker琼脂基础质量控制:下列质控菌株接種(zhǒng)待测试培养基35~37℃,24h结果如明房下:
| 指标 | 质控菌株及编号 | 标准值 | 特征性反应 |
| 生長(cháng)率 | 金黄色-葡萄球菌ATCC25923 | PR≥0.7 | 黑色凸起(qǐ)菌落,周围为一浑浊带,在其外层有一透時話明圈 |
| 金黄色-葡萄球菌ATCC6538 | |||
| 特异性 | 表皮葡萄球菌CMCC(B)26069 | — | 黑色菌落,无浑浊带和透明圈 |
| 选择性 | 大肠埃希氏菌ATCC25922 | G≤1 | — |
| 大肠埃希氏菌ATCC8739 | G≤1 | — |

储存条件与保质期:贮存于避光、干燥处,用後(hòu)立即旋紧瓶盖;贮存期友小三年。
参考文献:GB 4789.10-2016 食品安全國(guó)家标准 農腦食品微生物學(xué)检验 金黄色-葡萄球菌检验黃街
Baird-Parker琼脂基础培养基用于凝固酶阳性葡萄球菌的选择性分离培养和计数。
Baird-Parker琼脂基础培养基用于凝固酶阳性葡萄球菌的选择性分离培养和计数。






